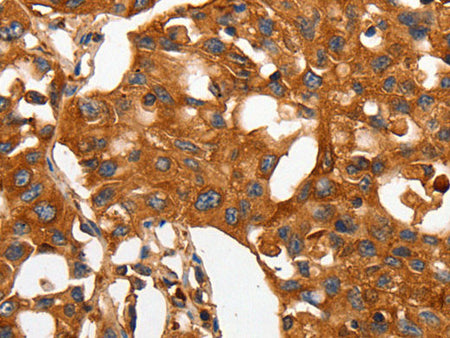
CAP2 Polyclonal Antibody Store at -20°C

CAP2 Polyclonal Antibody Store at -20°C
Couldn't load pickup availability

Still have questions? Ask our experts!
CAP2 Polyclonal Antibody Store at -20°C
| SKU # | E-AB-10200 |
| Reactivity | Human, Mouse, Rat |
| Host | Rabbit |
| Applications | WB, IHC |
Product Details
| Isotype | IgG |
| Host | Rabbit |
| Reactivity | Human, Mouse, Rat |
| Applications | WB, IHC |
| Clonality | Polyclonal |
| Immunogen | Recombinant protein of human CAP2 |
| Abbre | CAP2 |
| Synonyms | 2810452G09Rik, Adenylyl cyclase associated protein 2, Adenylyl cyclase-associated protein 2, CAP, CAP 2, CAP adenylate cyclase associated protein 2, CAP adenylate cyclase-associated protein 2, adenylate cyclase associated p, adenylate cyclase associated protein 2 |
| Swissprot | |
| Calculated MW | 53 kDa |
| Cellular Localization | Cell membrane. |
| Concentration | 0.4 mg/mL |
| Buffer | Phosphate buffered solution, pH 7.4, containing 0.05% stabilizer and 50% glycerol. |
| Purification Method | Affinity purification |
| Research Areas | Signal Transduction |
| Conjugation | Unconjugated |
| Storage | Store at -20°C Valid for 12 months. Avoid freeze / thaw cycles. |
| Shipping | The product is shipped with ice pack,upon receipt,store it immediately at the temperature recommended. |
Related Reagents
| Applications | Recommended Dilution |
| WB | 1:200-1:1000 |
| IHC | 1:50-1:200 |
Background
This gene was identified by its similarity to the gene for human adenylyl cyclase-associated protein. The function of the protein encoded by this gene is unknown. However, the protein appears to be able to interact with adenylyl cyclase-associated protein and actin.